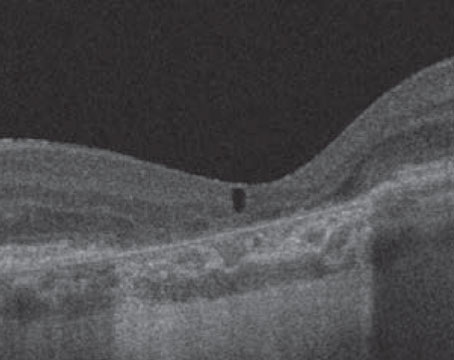

July / August 2021
Features

A closer look at emerging drug-delivery platforms
An update on Port Delivery System with ranibizumab, a large-molecule anti-VEGF candidate and subretinal gene therapy to treat neovascular AMD.

Retinal implant platforms moving from uveitis to AMD
Treatments show potential for various posterior-segment diseases based on their success treating noninfectious uveitis.
Using OCT to evaluate fluid in non-neovascular AMD
How optical coherence tomography, OCT angiography and fluorescein angiography can help direct diagnosis and treatment decisions.

Five emerging treatments show mixed results
Uncertainty about PVL for VMT and aflibercept for NPDR, some clarity on PDT, and early promise for stem cells and a bioresorbable implant.
Departments
Clinical Trial Closeup
Targeting headwaters of classical pathway
The IgG antibody fragment ANX007 aims to disrupt the cascade that leads to geographic atrophy at the initiating molecule.
Coding Commentary
Is your ‘new normal’ compliant?
A compliance plan can be more than meeting a mandate. It can improve your operations. Here’s a nuts-and-bolts approach.
Editor's Page
News
North of the Border
Using a hAM plug for large macular holes
Human amniotic membrane can be a vision-saving option for macular holes larger than 800 µm.
Retina Rounds
A tale of two hydroxychloroquine patients
Two cases demonstrate the spectrum of retinal findings in HCQ retinal toxicity as well as the role of multifocal electroretinogram in detecting the condition.
Social Media Specialist
Agency and advocacy in the digital world
How to utilize social media for patient advocacy and health promotion.
Surgical Pearl Video
Removing thick subretinal PVR bands
Subretinal proliferation is a well-known component of proliferative vitreoretinopathy. Here’s how to deal with it.



